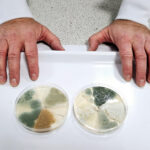
« Sensorial » – Des scientifiques découvrent comment créer différentes couleurs de fromage SciTechDaily

Les scientifiques Erle Ellis ont synthétisé la recherche interdisciplinaire pour illustrer comment les pratiques culturelles humaines ont historiquement permis la transformation des écosystèmes, passant de l’utilisation du feu au développement de chaînes d’approvisionnement mondiales. Soulignant les défis environnementaux de l’Anthropocène, tels que le changement climatique et la perte de biodiversité, Ellis plaide pour tirer parti des capacités sociales et culturelles de la société humaine vers une coexistence durable avec la nature, en mettant l’accent sur la coopération et la réimagination de notre relation avec l’environnement pour un avenir meilleur.
Rassemblant un éventail d’études interdisciplinaires portant sur l’archéologie, l’écologie, l’anthropologie et la théorie de l’évolution, Erle Ellis, professeur de géographie et de systèmes environnementaux à l’Université du Maryland, comté de Baltimore, explique l’évolution des pratiques culturelles qui ont permis aux sociétés de développer des capacités sans précédent. pour intensifier et transformer les systèmes écologiques qui les soutiennent.
De l’utilisation du feu pour cuire les aliments et gérer la végétation aux technologies et institutions qui soutiennent l’agriculture intensive, en passant par les sociétés de plus en plus urbanisées et les chaînes d’approvisionnement mondiales s’étendant à travers la planète, les sociétés humaines ont développé les capacités sociales, culturelles et écologiques nécessaires pour remodeler la planète et pour prospérer dans le processus.
Ellis est un scientifique de premier plan qui étudie l’Anthropocène, l’ère géologique actuelle définie par la transformation humaine de la planète. Il est le fondateur et directeur du Laboratoire d’Anthroécologie, qui étudie les relations entre les sociétés humaines et les écosystèmes aux échelles locale et planétaire dans le but de guider des relations humaines plus durables avec la biosphère. Il est actuellement chercheur invité à l’Oxford Martin School, où il a récemment présenté ses travaux sur les opportunités de l’Anthropocène.
Vers un avenir meilleur
Alors que les sociétés humaines ont acquis des capacités sans précédent pour améliorer la qualité et la longévité des vies humaines, Ellis montre que les conséquences involontaires de ces progrès ont généralement été négatives pour le reste de la vie sur Terre, du changement climatique aux espèces extinctions à une pollution de plus en plus répandue. Ces défis environnementaux perturbateurs de l’Anthropocène exigent des mesures si l’on veut garantir un avenir meilleur, tant pour les humains que pour le reste de la nature.
Pourtant, comme le démontre Ellis, décrire l’Anthropocène comme une crise environnementale ignore son message le plus important. Lorsque les gens travaillent ensemble, ils peuvent effectivement améliorer le monde. L’urgence des défis environnementaux planétaires actuels ne signifie pas que les récits de crise, de limites et d’effondrement environnementaux seront plus efficaces pour rassembler les gens pour façonner un avenir meilleur. Pour réussir, les efforts visant à façonner un avenir meilleur à long terme nécessitent d’exploiter les capacités sociales sans précédent des sociétés humaines et de permettre leur application par le biais d’aspirations humaines largement partagées.
Se connecter les uns aux autres et à la nature
Ellis évalue les limites des sciences naturelles pour prévoir et gérer avec succès les changements transformateurs sans précédent dans les sociétés, les environnements et les interactions qui illustrent la condition de l’Anthropocène. Les capacités qui ont toujours permis aux sociétés humaines de survivre et même de prospérer dans des conditions environnementales difficiles sont plutôt sociales et culturelles, fondées sur les institutions, les pratiques et les récits qui permettent des efforts de coopération pour soutenir le bien commun. Et si nous voulons un avenir meilleur pour le reste de la nature, ces capacités sociales et culturelles doivent être étendues au-delà des sociétés humaines.
« Remettre l’accent sur les relations de parenté entre tous les êtres vivants – notre ascendance évolutive commune – est un début, combiné à de nouvelles façons de connecter les gens et la nature, de la télédétection aux webcams, en passant par les applications sur la nature, les réserves de conservation communautaires, les réseaux de corridors et l’écotourisme », partage Ellis. « Les aspirations à un avenir meilleur doivent également faire la paix avec le passé grâce à la restauration de la souveraineté autochtone et traditionnelle sur les terres et les eaux. »
Ellis souligne que les capacités sociétales nécessaires pour façonner un avenir bien meilleur que celui qu’elles façonnent actuellement existent depuis des décennies. La clé pour les mettre en œuvre est de motiver leur mise en œuvre en faisant mieux comprendre au public que ces capacités non seulement existent mais peuvent être mises en œuvre avec succès grâce à la puissance planétaire sans précédent de nos aspirations humaines communes à vivre dans un monde meilleur.